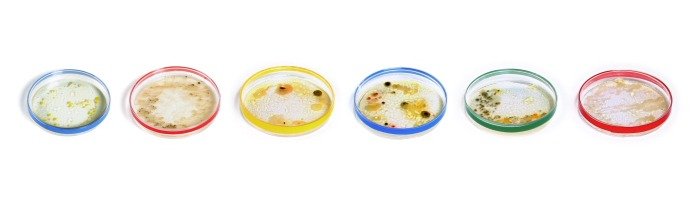
Google Doodle Julis Richard Petri

Google Doodle für Julius Richard Petri
Der Name Julius Richard Petri dürfte vielen nicht wirklich was sagen, aber seine Erfindung dürften viele kennen: Die Petrischale.
Julius Richard Petri wurde am 31. Mai 1852 in Barmen geboren. Während der Arbeit mit Robert Koch erfand er die nach ihm benannte Petrischale. In dieser findet sich eine
Mit einem interaktiven Google Doodle feiert das Unternehmen heute auf den meisten Startseite von Google den 161. Geburtstag von Petri. Jeder Buchstabe des Logos stellt eine Petrischale dar. Jede Schale stellt eine Kultur von Bakterien dar, denen man im Alltag begegnet. Zum Beispiel eine Tastatur, schmutzigen Socken oder einem Spülschwamm.
Der Bakteriologe war ab 1889 Mitglied des Kaiserlichen Gesundheitsamtes und Leiter eines Labors. Petri wurde 69 Jahre alt und verstarb im Dezember 1922.
GoogleWatchBlog bei Google News abonnieren | GoogleWatchBlog-Newsletter
In dieser findet sich eine
Mit
Öhm, hier fehlt doch eindeutig noch etwas Text 🙂